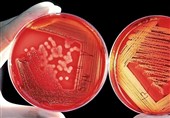
شناسایی راه تازه‌ درمان سرطان با استفاده از نانوذرات سیلیکونی

مرکز تحقیقات سرطان (انیستیتوکانسر ایران) | خبرگزاری تسنیم | Tasnim


ابتلای سالانه 131000 نفر به سرطان/کشندهترین سرطانهای کشور
طبق آخرین بررسیهای انستیتو کانسر ایران از روند شیوع سرطان در کشور در سال 1399، تعداد 131 هزار و 191 مورد ابتلا به سرطان در سال بروز پیدا کرده که منجر به مرگ بالغ بر 79 هزار نفر در کشور شده است و برخی سرطانها در صدر جدول آمار مرگ و میر قرار دارند.

مرگ روزانه 200 بیمار سرطانی/ رتبه 48 ایران در رشد سرطان
معاون پژوهشی پژوهشکده سرطان دانشگاه علوم پزشکی تهران با اشاره به مرگ روزانه 200 بیمار مبتلا به سرطان در کشور گفت: ایران به لحاظ روند رو به رشد بروز سرطان بین کشورهای جهان رتبه 48 را دارد.

آنچه باید درباره بیماری سرطان بدانیم/ سرطان پایان راه نیست
فوقتخصص بیماریهای خون و سرطان بزرگسالان، درباره علل بروز سرطان، روشهای تشخیص و درمان این بیماری توضیح میدهد.

بازدید پزشکان هندی از دستاورد بزرگ دانشمندان ایرانی
با تلاش و همکاری ستاد نانو معاونت علمی یک هیئت هندی با حضور در بیمارستان امام خمینی(ره) از نزدیک با عملکرد دستگاه CDP(دستگاه تشخیص سلولهای سرطانی) ساخت دانشمندان ایرانی(پروفسور عبدالاحد) آشنا شدند.

موفقیت دانشگاه علوم پزشکی تهران در تولید 180 محصول فناورانه
رئیس دانشگاه علوم پزشکی تهران گفت: تاکنون 180 محصول فناورانه و صدها دارو در دانشگاه علومپزشکی تهران تولید شده و علت این موفقیت آن است که دانشگاه در کنار صنعت قرار گرفته است.

احتمال رشد 3 برابری آمار سرطان در 20 سال آینده/ ابتلای سالانه 16000 زن ایرانی به سرطان سینه
فلوشیپ جراحی بیماریهای پستان با اشاره به احتمال دو تا سه برابر شدن آمار سرطان در کشور تا 20 سال آینده گفت: در بین زنان ایرانی، سرطان سینه شایعترین سرطان است که سالانه حدود 15 تا 16 هزار نفر را درگیر میکند.

چه عواملی باعث افزایش احتمال ابتلا به سرطانهای دهان میشود؟
رئیس هجدهمین کنگره بینالمللی جراحان فک، دهان و صورت با بیان اینکه سرطانهای این ناحیه، شایعاند، گفت: مصرف برخی داروهای درمان پوکی استخوان اگرچه عوارض پوکی استخوان را کاهش میدهد اما ممکن است باعث بروز عفونت و تأخیر در ترمیم استخوان دهان شود.

سرعت رشد سرطان در ایران بسیار بالاتر از سایر کشورها/ ایران جزو 4 کشور پیر آینده جهان!
رییس مرکز تحقیقات سرطان دانشگاه علوم پزشکی شهید بهشتی با بیان اینکه سرعت رشد سرطان در کشور ما بسیار بالاتر از سایر کشورهای دنیاست، گفت: در آینده جزو چهار کشور پیر جهان خواهیم شد!

"شرکتهای دارویی" دومین قدرت اقتصادی جهان پس از اسلحهسازی!
مشاور عالی وزیر بهداشت با بیان اینکه استفاده از داروهای شیمی درمانی، کمترین اثربخشی را نسبت به سایر روشهای درمان سرطان دارد، گفت: امروزه شرکتهای دارویی پس از شرکتهای اسلحهسازی دومین قدرت اقتصادی جهان را دارند!

"عوامل محیطی" به میزان 90 درصد در پیدایش سرطانها مؤثرند
دبیر علمی پنجمین کنگره بینالمللی سرطانهای دستگاه گوارش با بیان اینکه حدود یک سوم سرطانهای کشور، سرطانهای دستگاه گوارش هستند، گفت: عوامل محیطی، به میزان 90 درصد در پیدایش سرطانها مؤثرند.

کشف کلید درمان تمام سرطانها
طی دهههای اخیر سرطانهای گوناگونی در بدن انسان کشف شده است که برای درمان هر کدام روشها متنوعی وجود دارد اما دانشمندان به تازگی روشی واحد کشف کردند که میتواند درمانگر انواع سرطان باشد.

کاهش ریسک ابتلا به 7 نوع سرطان با انجام این کار ساده!
افزایش نرخ ابتلا به سرطان حساسیتهای جامعه پزشکی را برای جلوگیری از ابتلای افراد جامعه افزایش داده و این در حالیست که برخی فعالیتهای ساده میتواند مانع از ابتلای افراد به انواع مختلف سرطان شود!

بیش از 6500 کودک محک، سرطان را شکست دادهاند
مدیرعامل محک با بیان اینکه بیش از 6500 کودک مبتلا به سرطان تا پایان سال 1397 بهبود یافتهاند، گفت: روزانه 6 کودک جدید نیز به جمع کودکان تحت حمایت محک اضافه میشود؛ سرانه هزینه درمان در سال 97 با 21.5 درصد رشد نسبت به سال 96 روبرو بوده است.

مسائل فرهنگی از علل ضعف در غربالگری "سرطان سینه"
یک متخصص رادیوتراپی انکولوژی با بیان اینکه سرطان سینه از شایعترین سرطانها در بین زنان است، گفت: مسائل فرهنگی درباره غربالگری سرطان سینه در بین زنان از علل ضعف در غربالگری این بیماری است؛ تاسیس مراکز طب تسکینی نیازمند حمایت دولت و خیریههاست.

"سرطان خاموش" چگونه قربانی خود را میکُشد!
یک متخصص جراحی دستگاه گوارش با تشریح یکی از خطرناکترین سرطانهای جهان گفت: این سرطان که به "سرطان خاموش" معروف است تا زمانی که به مراحل خطر نرسیده معمولاً علامتی ندارد یا بهدلیل ساده بودن علائم این بیماری، بیمار علائم آن را جدی تلقی نمیکند!

کشفی تازه برای شناسایی سریع اوتیسم و سرطان در کودکان
شناسایی سریع اوتیم و سرطان در کودکان میتواند مراحل درمان را برای آنها بسیار سادهتر کند و به همین دلیل دانشمندان توانستند با استفاده از ساعت ملکولی بدن، این دو بیماری را بهسرعت در بدن کودکان تشخیص دهند.
شناسایی راه تازه درمان سرطان با استفاده از نانوذرات سیلیکونی
نانوذرات سیلیکونی راه تازهای است که محققان برای درمان سرطان کشف کردهاند.

چرا خوردن "نان سفید" خطرناک است؟
بررسیها نشان میدهد در صورتی که گندم و برنج "سفید" شده باشد فاقد "قند ویتامینهای گروه B" خواهند بود که در نتیجه باعث بروز بیماریهای خطرناکی میشود...
